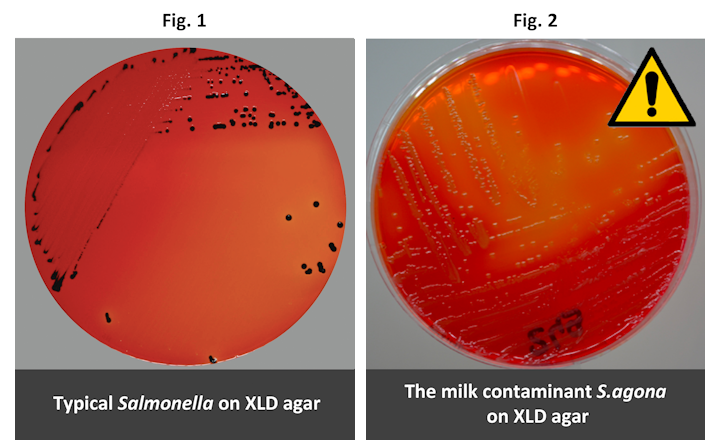

The particular strain of Salmonella implicated in the recent contamination of infant formula milk, is from the S.agona species group and has very unusual behaviour on XLD, ie non-alkalinisation of the medium and no H2S reaction. These characteristics lead to an atypical colony appearance on this media.
These Salmonella colonies are yellow without the black dot (see Fig.2 above), instead of the expected red with a black dot for a typical Salmonella (see Fig.1 above). Such colony characteristics on XLD would result in these Salmonella isolates being reported as a false negative (as their appearance is typical of a coliform isolate).
As shown below when grown on Rambach™ agar (see Fig. 3) and CHROMagar™ Salmonella Plus (see Fig. 4), this particular strain has the same colony appearance as other Salmonella isolates – distinctive red colonies.
Because of the risks associated with reporting false negative results with such atypical Salmonella strains, ISO-6579 (Microbiology of the food chain - Salmonella) requires laboratories to use XLD agar and a second selective media of your choosing. Rambach™ agar or CHROMagar™ Salmonella Plus are the perfect complement!